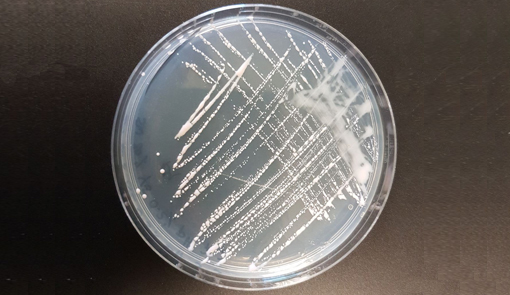

"Claves de la innovación"

Matt Ridley es uno de los ensayistas más atractivos e interesantes de lo que llevamos de siglo porque nos hace pensar en la enorme cantidad de sesgos y datos sin contrastar con los que nos manejamos, desde periodistas a sociólogos y, en general, la inmensa mayoría de la población que opinamos con frecuencia sin más hechos que prejuicios e informaciones mal oídas e interpretadas, con frecuencia difundidas en las pantallas.
T´ítulo: "Claves de la innovación"
Autor: Matt Ridley
Editorial: Antoni Bosch Editor
Su primer impacto fue "Genoma: La autobiografía de una especie en 23 capítulos", y os he hablado de "El optimista racional", contradiciendo muchos de los tópicos que nos alimentan, desde las energías renovables hasta los datos sobre la marcha de las sociedades del mundo. Acaba de publicarse su último trabajo, "Las claves de la innovación", donde de nuevo recompone buena parte de lo que nos llega desde los medios de comunicación tradicionales, no digamos ya los que pretenden orientar nuestras ideologías, es decir, la mayoría.
 Su nuevo libro nos lleva por los avances históricos y científicos que nos han hecho lo que somos. Ridley repasa nuestra Historia con su amenidad y habilidad habituales. Nos conduce desde el fuego y la alimentación hasta la energía nuclear, desde el transporte hasta las patatas; desde el enorme invento que supuso el sifón en los retretes hasta los pollos de Pasteur; desde el invento del contenedor que transformó el comercio hasta las maletas con ruedas. Todo ello con el manejo habitual y sorprendente de datos contrastados procedentes de organismos internacionales.
Su nuevo libro nos lleva por los avances históricos y científicos que nos han hecho lo que somos. Ridley repasa nuestra Historia con su amenidad y habilidad habituales. Nos conduce desde el fuego y la alimentación hasta la energía nuclear, desde el transporte hasta las patatas; desde el enorme invento que supuso el sifón en los retretes hasta los pollos de Pasteur; desde el invento del contenedor que transformó el comercio hasta las maletas con ruedas. Todo ello con el manejo habitual y sorprendente de datos contrastados procedentes de organismos internacionales.
Ridley es de una amenidad que corresponde con su presidencia de la asociación divulgativa y del International Centre of Life en el Reino Unido dedicado a la difusión de la ciencia, y son muchas las veces en que apetece tener algo a mano con lo que subrayar, para luego contarlo a los amigos.
Ridley advierte que hay una gran diferencia entre invento e innovación, aunque en algunos casos ambos pueden encontrarse. Aunque él no lo emplea en este caso, un buen ejemplo es la pieza que usamos para manejar el ordenador con una sola mano. El ratón fue inventado por Rank Xerox, pero no fue innovación hasta que Steve Jobs compró la patente por mil dólares y lo modificó para transformarlo en lo que es. "Tiene que funcionar incluso sobre mis vaqueros" dijo a sus técnicos.
Los libros de Ridley son a cada cual más interesantes para quienes amamos la Historia y la ciencia. Merecen ser leídos y difundidos. En el mundo anglosajón se espera con interés cada una de las obras de este divulgador y biólogo de Oxford y es conocido por su labor en diarios como The Economist o The Daily Telegraph, donde escribe sobre temas dedicados a la ciencia.
Un ejemplo extraído del libro podría poneros dos decenas de casos sorprendentes y poco conocidos, afecta a nuestro país y está en relación con el avance científico que ha permitido hacer la vacuna contra la pandemia actual en un tiempo mínimo, tal vez sea el hallazgo más relevante de la Historia de la humanidad hasta el momento porque significa la posibilidad de modificar, recrear o adaptar a todos los seres vivos del planeta.
"Los descubrimientos científicos más útiles van acompañados casi siempre (con una frecuencia ridícula) de disputas furibundas sobre a quién le corresponde el mérito. En ningún caso es esto más cierto que en la historia del editor genético CRISPR, una técnica con la que el mundo se despertó en 2012 y que promete resultados fabulosos tanto en la agricultura como en la medicina. La disputa se agudizó en este caso porque enfrenta a dos grandes universidades estadounidenses situadas en costas opuestas: Berkeley, en California, y el MIT, en Massachusetts. Sin embargo, podría decirse que ninguna de estas dos inmensas universidades estadounidenses, con sus grandes presupuestos y lujosos laboratorios, merecen tanto crédito como reclaman, porque más bien le correspondía a un par de microbiólogos desconocidos que trabajan en cuestiones prácticas relacionadas con las bacterias pero que no están de moda: uno desde un laboratorio universitario para resolver un problema que interesa a la industria de la sal, y el otro desde una empresa fabricante de alimentos. El camino recorrido desde el descubrimiento de una curiosidad bioquímica hasta el desarrollo de una tecnología es, como siempre, largo y sinuoso, y en este caso no discurre desde el mundo académico hacia la industria sino, al menos en parte, en la dirección opuesta.
Cerca de la ciudad de Alicante, en España, hay un gran lago rosáceo frecuentado por flamencos de un color rosa aún más intenso. La Laguna Salada de Torrevieja se encuentra por debajo del nivel del mar, abarca 1.400 hectáreas y se ha usado durante tres siglos para extraer sal. En junio se permite que el agua del mar entre en el lago y, a lo largo del verano, a medida que el agua se evapora, la sal cristaliza en el fondo de la laguna y se recolecta con máquinas especiales para refinarla y venderla: 700.000 toneladas al año. El color rosa se debe a microorganismos amantes de la sal de dos tipos, bacterias y arqueas, que sirven de alimento a quisquillas de color rosa que, a su vez, dan de comer a los flamencos.
Cerca de la ciudad de Alicante, en España, hay un gran lago rosáceo frecuentado por flamencos de un color rosa aún más intenso. La Laguna Salada de Torrevieja se encuentra por debajo del nivel del mar, abarca 1.400 hectáreas y se ha usado durante tres siglos para extraer sal. En junio se permite que el agua del mar entre en el lago y, a lo largo del verano, a medida que el agua se evapora, la sal cristaliza en el fondo de la laguna y se recolecta con máquinas especiales para refinarla y venderla: 700.000 toneladas al año. El color rosa se debe a microorganismos amantes de la sal de dos tipos, bacterias y arqueas, que sirven de alimento a quisquillas de color rosa que, a su vez, dan de comer a los flamencos.
No es de extrañar que el Departamento de Fisiología, Genética y Microbiología de la Universidad de Alicante haya usado este recurso para estudiar los microorganismos amantes de la sal (halófilos) que viven en la laguna. Una arquea llamada Haloferax Mediterranei se descubrió por primera vez en Alicante.
Francisco Mojica, nacido en Elche, se doctoró en la Universidad de Alicante en el año 1993 estudiando los genes de esta criatura y, durante sus indagaciones, detectó algo bastante extraño: parte del genoma de aquel organismo ocultaba una secuencia llamativa de treinta letras que se repetía una y otra vez, de tal modo que cada repetición estaba separada por una secuencia de entre 35 y 39 letras siempre distinta. La secuencia repetida solía ser un palíndromo, o sea, arrojaba el mismo texto leída hacia delante que hacia atrás. Mojica examinó otro microbio emparentado y también amante de la sal, y encontró un patrón casi idéntico, si bien con una secuencia diferente. Después volvió a detectarla en veinte microorganismos distintos, tanto bacterias como arqueas. Mojica dedicó los diez años siguientes a intentar explicar a qué se debía el patrón. La mayoría de sus hipótesis se revelaron erradas. Un científico holandés, Ruud Jansen, señaló que siempre había determinados genes cerca del curioso texto, los llamados genes Cas. Jansen acuñó el nombre del patrón: «clustered regularly interspaced palindromic repeats» (es decir, «repeticiones palindrómicas concentradas e inteiespaciadas con regularidad») o CRISPR para abreviar.
Entonces, un día de 2003, Mojica tuvo un golpe de suerte. Tomó uno de los «espaciadores», o secuencias no repetidas, que separaban cada uno de los palíndromos de una bacteria intestinal y lo introdujo en un banco de datos de secuencias genéticas para ver si se correspondía con alguna. Y ¡eureka! obtuvo respuesta: coincidía con el gen de un virus, en concreto, de un virus denominado «fago» para abreviar. Partículas diminutas, que a veces tienen el aspecto de un módulo de aterrizaje lunar de las misiones Apolo en miniatura.
Mojica tardó más de un año en publicar sus resultados debido al desprecio de las revistas de prestigio por un descubrimiento relevante procedente de un científico Don Nadie que ejerce en un páramo como Alicante".
Mojica pudo, tal vez debió, ser el que recibiera el Nobel que dieron a dos investigadoras de Berkley por las "tijeras genéticas" que están comenzando a revolucionar la vida, aunque aún tardaremos algunos años en que el poder de su impacto llegue al público en general.
Leer a Ridley es toda una inversión en conocimiento y buena información, aunque ya os digo que os hará arrugar la frente en más de una ocasión, porque desmonta lugares comunes que tenemos instalados con fuerza.
Carlos López-Tapia


















